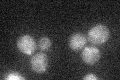
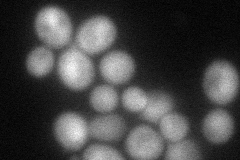
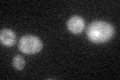

View description
Nuclear encoded protein needed for efficient splicing of mitochondrial COX1 aI5beta intron; mss18 mutations block cleavage of 5' exon - intron junction; phenotype of intronless strain suggests additional functions
Localization:
Intensity:
Fold change:
Significance:
-
C’ GFP library in SD
mitochondria16.92 -
N' NOP1pr-GFP in SD

cytosol59.878 -
N' TEF2pr-mCherry in SD
vacuole67.0588 -
N' NATIVEpr-GFP in SD

below threshold21.556 -
N' TEF2pr-VC and Cyto-VN in SD

#N/A0 -
C’ GFP library in SD+DTT
mitochondria19.281.13No -
C’ GFP library in SD+H2O2

mitochondria17.531.03No -
C’ GFP library in Starvation Media

mitochondria21.841.29No -
C’ GFP library on the background of Pup2-DaMP

mitochondria -
C’ GFP library on the background of CCT mutant

mitochondria16.54390.977126No
